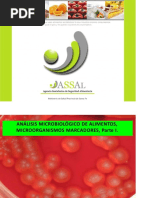

0% encontró este documento útil (0 votos)
806 vistas14 páginasElaboración del Chorizo Criollo
Este documento describe el proceso de elaboración del chorizo criollo. Explica que el chorizo es un embutido crudo de carne picada de cerdo altamente condimentado. Detalla los ingredientes clave como la carne, grasa, sal, nitratos, nitritos y especias usadas y sus propiedades. Además, provee información nutricional sobre diferentes tipos de carne.
Cargado por
Miguel Angel Muñoz BosquezDerechos de autor
© © All Rights Reserved
Nos tomamos en serio los derechos de los contenidos. Si sospechas que se trata de tu contenido, reclámalo aquí.
Formatos disponibles
Descarga como DOCX, PDF, TXT o lee en línea desde Scribd
0% encontró este documento útil (0 votos)
806 vistas14 páginasElaboración del Chorizo Criollo
Este documento describe el proceso de elaboración del chorizo criollo. Explica que el chorizo es un embutido crudo de carne picada de cerdo altamente condimentado. Detalla los ingredientes clave como la carne, grasa, sal, nitratos, nitritos y especias usadas y sus propiedades. Además, provee información nutricional sobre diferentes tipos de carne.
Cargado por
Miguel Angel Muñoz BosquezDerechos de autor
© © All Rights Reserved
Nos tomamos en serio los derechos de los contenidos. Si sospechas que se trata de tu contenido, reclámalo aquí.
Formatos disponibles
Descarga como DOCX, PDF, TXT o lee en línea desde Scribd